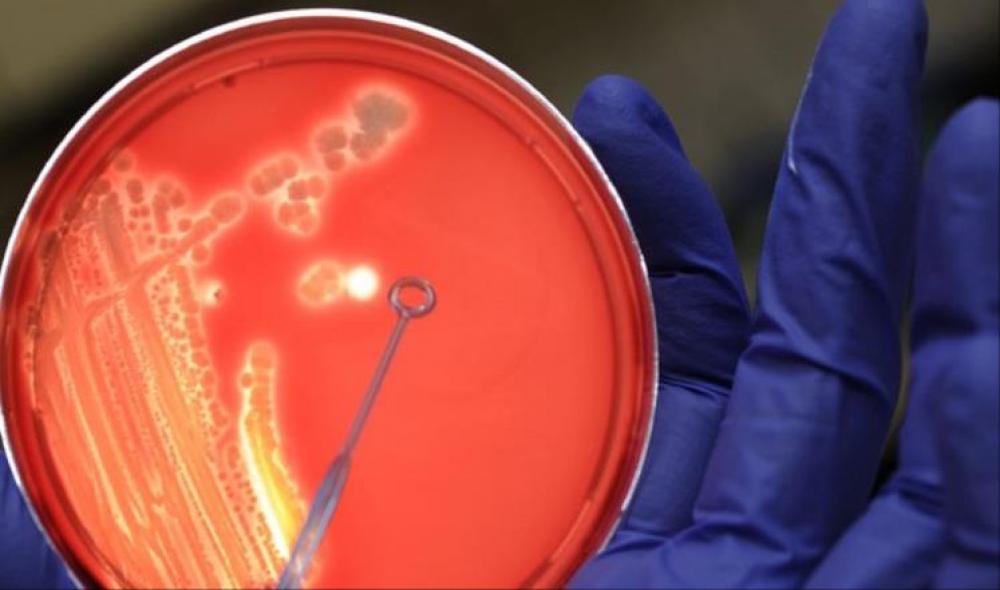
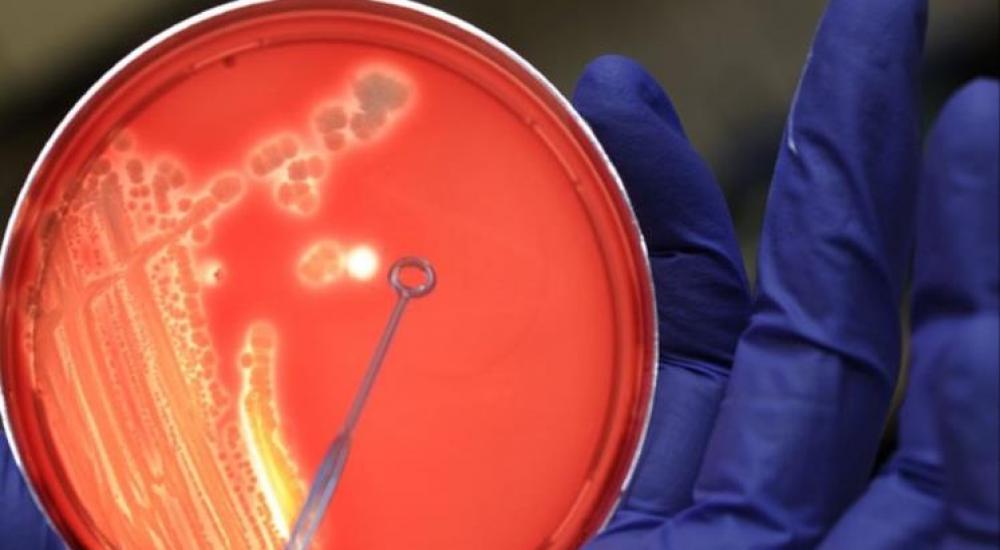

باريس
رجّح باحثون فرنسيون أن نوعية معينة من البكتيريا المعوية لدى الإنسان تؤثر في إحساسه بالشبع.
وأظهر الباحثون في تجارب أجروها على الحيوانات والخلايا أن البكتيريا المعوية المعروفة باسم "الإشريكية القولونية"، ترسل -بعد مرور بعض الوقت على تناول الطعام- إشارات تتسبب في تحفيز الشعور بالشبع وتحد من استقبال طعام آخر.
وسوف يعرض الباحثون الفرنسيون تحت إشراف الباحث الفرنسي جوناثان بريتون من المعهد الوطني الفرنسي للصحة والأبحاث الطبية في مدينة روان الفرنسية، عملهم في المجلة العلمية المتخصصة "سيل ميتابوليزم".
وعلق ميشائيل بلاوت من المعهد الألماني لأبحاث التغذية في مدينة بوتسدام على هذه الدراسة، قائلا إنها تجارب مثيرة للاهتمام، ولكنه استدرك قائلا "لكنني أرى أنه تم تأويل البيانات على نحو مبالغ فيه".
المصدر : الألمانية